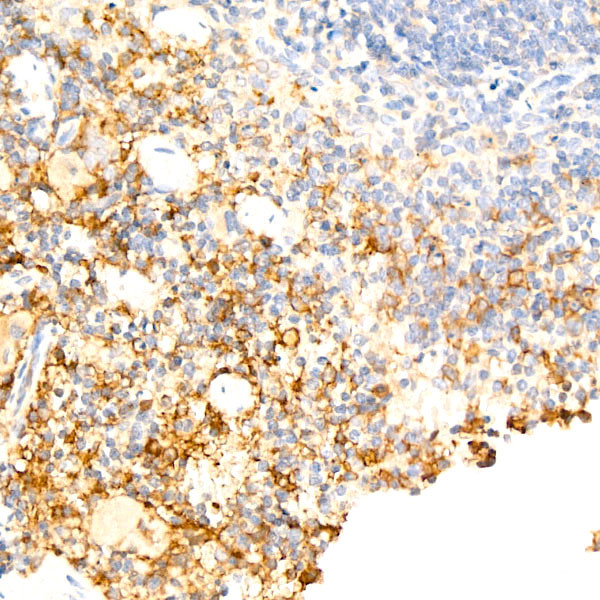
F4/80 Antibody in Immunohistochemistry (Paraffin) (IHC (P))

Search
Invitrogen
F4/80 Recombinant Rabbit Monoclonal Antibody (4J7L6)
{{$productOrderCtrl.translations['antibody.pdp.commerceCard.promotion.promotions']}}
{{$productOrderCtrl.translations['antibody.pdp.commerceCard.promotion.viewpromo']}}
{{$productOrderCtrl.translations['antibody.pdp.commerceCard.promotion.promocode']}}: {{promo.promoCode}} {{promo.promoTitle}} {{promo.promoDescription}}. {{$productOrderCtrl.translations['antibody.pdp.commerceCard.promotion.learnmore']}}
图: 1 / 3
F4/80 Antibody (MA5-55206) in IHC (P)



Please note: We are reviewing Western blot images included in the antibody testing data in our catalog, including those provided by third parties. Unless expressly labeled or annotated as “raw-unedited”, Western blot images included in the antibody testing data in our catalog may have been edited, optimized or otherwise adjusted for presentation.
产品信息
MA5-55206
种属反应
宿主/亚型
Expression System
分类
类型
克隆号
抗原
偶联物
形式
浓度
规格
纯化类型
保存液
内含物
保存条件
RRID
产品详细信息
Immunogen Sequence: KRILFKCKED LILQSEQIQQ CQAVQGRDLG YASFCTLVNA TFTILDNTCE NKSAPVSLQS AATSVSLVLE QATTWFELSK EETSTLGTIL LETVESTMLA ALLIPSGNAS QMIQTEYLDI ESKVINEECK ENESINLAAR GDKMNVGCFI IKESVSTGAP GVAFVSFAHM ESVLNERFFE DGQSFRKLRM NSRVVGGTVT GEKKEDFSKP IIYTLQHIQP KQKSERPICV SWNTDVEDGR WTPSGCEIVE ASETHTVCSC NRMANLAIIM ASGELTMEF
靶标信息
F4/80 antigen is a 160 kDa cell surface glycoprotein that is a member of the EGF TM7 family of proteins and shares 68% overall amino acid identity with human EGF module containing mucin like hormone receptor 1 (EMR1). Expression of F4/80 is heterogeneous and is reported to vary during macrophage maturation and activation. The F4/80 antigen is expressed on a wide range of mature tissue macrophages including Kupffer cells, Langerhans, microglia, macrophages located in the gut lamina propria, peritoneal cavity, lung, thymus, bone marrow stroma and macrophages in the red pulp of the spleen. F4/80 expression has also been reported on a subpopulation of dendritic cells but is absent from macrophages located in T cell areas of the spleen and lymph node. The ligands and biological functions of the F4/80 antigen have not yet been determined but recent studies suggest a role for F4/80 in the generation of efferent CD8+ve regulatory T cells.
仅用于科研。不用于诊断过程。未经明确授权不得转售。
篇参考文献 (0)
生物信息学
蛋白别名: Adhesion G protein-coupled receptor E1; Cell surface glycoprotein F4/80; EGF-like module containing, mucin-like, hormone receptor-like sequence 1; EGF-like module receptor 1; EGF-like module-containing mucin-like hormone receptor-like 1; EMR1 hormone receptor; lymphocyte antigen 71
基因别名: Adgre1; DD7A5-7; EGF-TM7; Emr1; F4/80; Gpf480; Ly71; TM7LN3
UniProt ID: (Mouse) Q61549
Entrez Gene ID: (Mouse) 13733